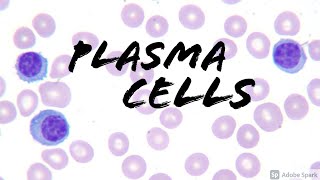
Plasma Cells on Peripheral Blood Smear (Hemepath Hematology Pathology) screenshot 5

血液ボードのレビュー
血液板を200試験スタイルの質問、推進、詳細な進歩で渡します。
Springer Publishingによってあなたに連れて行かれ、このアプリは、試験青写真で扱われているすべてのトピックのアウトラインベースのレビューとともに、答えのある200のボードスタイルの質問、詳細な推進、および参照を備えています。血液ボードのレビューはあなたのボードを渡すためのあなたの包括的な解決策です。
無料版を今日インストールしてジャンプ勉強を始めましょう!
アップグレードを決定する前に試すことができるコンテンツの限られた無料版を提供しました。このバージョンには、限られた量の練習問題と基本的な進捗メトリックが含まれています。
プレミアムバージョンにアップグレードすることで、アプリ内購入で最高の価値を得る。プレミアムバージョンには、次のものが含まれています。輸血医療、造血細胞移植、および標準的な治療計画
主なデータとステージング、治療の選択肢、および疾患の分類に関連する情報を提供するテーブル
モバイルアプリとウェブサイトへのアクセスを無料で含む - あなたの進歩を追跡しそして同期する3つのデバイス!
血液検査ボードレビューは、あなたがあなたの試験の準備をするのを助けるための完璧な訓練ソリューションです。無料で始めましょう!
©Springer Publishing
ご質問、提案、またはコメントがある場合は、medical@hltcorp.comまたは319-246-5299。